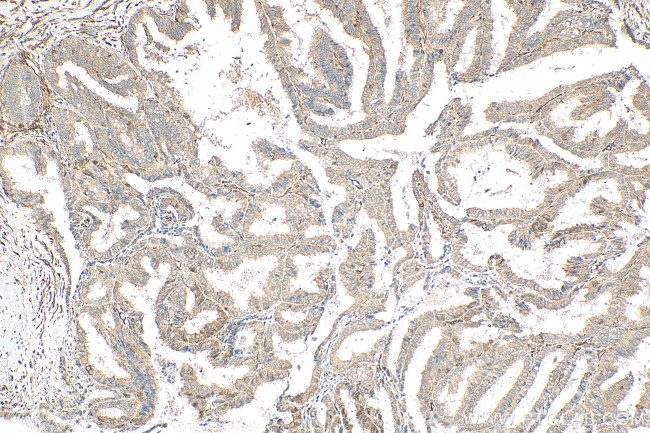
NCAPG Antibody in Immunohistochemistry (Paraffin) (IHC (P))

Search
Proteintech
NCAPG Polyclonal Antibody
{{$productOrderCtrl.translations['antibody.pdp.commerceCard.promotion.promotions']}}
{{$productOrderCtrl.translations['antibody.pdp.commerceCard.promotion.viewpromo']}}
{{$productOrderCtrl.translations['antibody.pdp.commerceCard.promotion.promocode']}}: {{promo.promoCode}} {{promo.promoTitle}} {{promo.promoDescription}}. {{$productOrderCtrl.translations['antibody.pdp.commerceCard.promotion.learnmore']}}
产品信息
29933-1-AP
种属反应
宿主/亚型
分类
类型
抗原
偶联物
形式
纯化类型
保存液
内含物
保存条件
运输条件
产品详细信息
Immunogen sequence: LLNEILEQVK DRTCLRALEK IKIQLEKGNK EFGDQAEAAQ DATLTTTTFQ NEDEKNKEVY MTPLRGVKAT QASKSTQLKT NRGQRKVTVS ARTNRRCQTA EADSESDHEV PEPESEMKMR LPRRAKTAAL EKSKLNLAQF LNEDLS
靶标信息
This gene encodes a subunit of the condensin complex, which is responsible for the condensation and stabilization of chromosomes during mitosis and meiosis. Phosphorylation of the encoded protein activates the condensin complex. There are pseudogenes for this gene on chromosomes 8 and 15. Alternative splicing results in multiple transcript variants.
仅用于科研。不用于诊断过程。未经明确授权不得转售。
篇参考文献 (0)
生物信息学
蛋白别名: CAP-G; chromosome condensation protein G; Chromosome-associated protein G; Condensin complex subunit 3; Condensin subunit CAP-G; FLJ12450; hCAP-G; Melanoma antigen NY-MEL-3; MGC126525; Non-SMC condensin I complex subunit G; unnamed protein product; XCAP-G homolog
基因别名: CAPG; CHCG; NCAPG; NY-MEL-3; NYMEL3; YCG1
UniProt ID: (Human) Q9BPX3
Entrez Gene ID: (Human) 64151